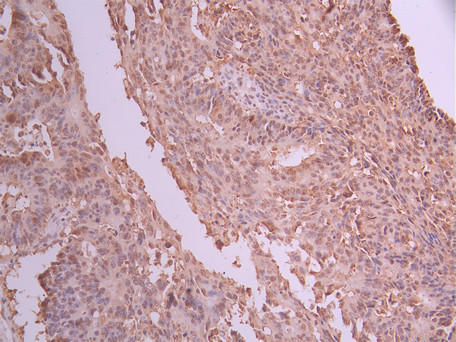

NME1 Recombinant Monoclonal Antibody
-
中文名稱:NME1 Recombinant Monoclonal Antibody
-
貨號:CSB-RA060362A0HU
-
規(guī)格:¥1320
-
圖片:
-
Western Blot
Positive WB detected in: A549 whole cell lysate(30μg), Hela whole cell lysate(30μg), MCF-7 whole cell lysate(30μg)
All lanes: NDK A antibody at 1:1000
Secondary
Goat polyclonal to rabbit IgG at 1/40000 dilution
Predicted band size: 17 kDa
Observed band size: 17 kDa
Exposure time:1min -
IHC image of CSB-RA060362A0HU diluted at 1:100 and staining in paraffin-embedded human colorectal cancer performed on a Leica BondTM system. After dewaxing and hydration, antigen retrieval was mediated by high pressure in a citrate buffer (pH 6.0). Section was blocked with 10% normal goat serum 30min at RT. Then primary antibody (1% BSA) was incubated at 4°C overnight. The primary is detected by a Goat anti-rabbit polymer IgG labeled by HRP and visualized using 0.05% DAB.
-
Overlay Peak curve showing SH-SY5Y cells stained with CSB-RA060362A0HU (red line) at 1:100. The cells were fixed in 4% formaldehyde and permeated by 0.2% TritonX-100 for 10min. Then 10% normal goat serum to block non-specific protein-protein interactions followed by the antibody (1ug/1*106cells) for 45min at 4℃. The secondary antibody used was FITC-conjugated goat anti-rabbit IgG (H+L) at 1/200 dilution for 35min at 4℃.Control antibody (green line) was Rabbit IgG (1ug/1*106cells) used under the same conditions. Acquisition of >10,000 events was performed.
-
-
其他:
產(chǎn)品詳情
-
Uniprot No.:
-
基因名:NME1
-
別名:Nucleoside diphosphate kinase A (NDK A) (NDP kinase A) (EC 2.7.4.6) (Granzyme A-activated DNase) (GAAD) (Metastasis inhibition factor nm23) (NM23-H1) (Tumor metastatic process-associated protein), NME1, NDPKA NM23
-
反應(yīng)種屬:Human
-
免疫原:A synthesized peptide from human NME1 protein
-
免疫原種屬:Homo sapiens (Human)
-
標(biāo)記方式:Non-conjugated
-
克隆類型:Monoclonal
-
抗體亞型:Rabbit IgG
-
純化方式:Affinity-chromatography
-
克隆號:4B12
-
濃度:It differs from different batches. Please contact us to confirm it.
-
保存緩沖液:Preservative: 0.03% Proclin 300
Constituents: 50% Glycerol, 0.01M PBS, PH 7.4 -
產(chǎn)品提供形式:Liquid
-
應(yīng)用范圍:ELISA, WB, IHC, FC
-
推薦稀釋比:
Application Recommended Dilution WB 1:500-1:2000 IHC 1:50-1:200 FC 1:50-1:200 -
Protocols:
-
儲存條件:Upon receipt, store at -20°C or -80°C. Avoid repeated freeze.
-
貨期:Basically, we can dispatch the products out in 1-3 working days after receiving your orders. Delivery time maybe differs from different purchasing way or location, please kindly consult your local distributors for specific delivery time.
-
用途:For Research Use Only. Not for use in diagnostic or therapeutic procedures.
相關(guān)產(chǎn)品
靶點(diǎn)詳情
-
功能:Major role in the synthesis of nucleoside triphosphates other than ATP. The ATP gamma phosphate is transferred to the NDP beta phosphate via a ping-pong mechanism, using a phosphorylated active-site intermediate. Possesses nucleoside-diphosphate kinase, serine/threonine-specific protein kinase, geranyl and farnesyl pyrophosphate kinase, histidine protein kinase and 3'-5' exonuclease activities. Involved in cell proliferation, differentiation and development, signal transduction, G protein-coupled receptor endocytosis, and gene expression. Required for neural development including neural patterning and cell fate determination. During GZMA-mediated cell death, works in concert with TREX1. NME1 nicks one strand of DNA and TREX1 removes bases from the free 3' end to enhance DNA damage and prevent DNA end reannealing and rapid repair.
-
基因功能參考文獻(xiàn):
- NME1 enhanced ALDOC transcription, evidenced by increased expression of ALDOC pre-mRNA and activity of an ALDOC promoter-luciferase module. This is the first study to indicate that NME1 induces transcription through its direct binding to the promoter region of a target gene. PMID: 30396920
- NME1 rs16949649 associated with increased susceptibility to gynecological cancer and rs2302254 was linked to reduced gastric cancer risk (Meta-Analysis) PMID: 29525404
- Immunohistochemical expression of nm23H1 is not an effective tool to distinguish among the cases of BPH, adenocarcinoma of prostate with and without metastasis. Hence nm23H1 gene does not behave like an antimetastatic gene in prostatic lesions. PMID: 29567887
- The positive expression rates of KAI1 and nm23 were significantly lower in laryngeal squamous cell carcinoma than normal laryngeal mucosa. PMID: 29187211
- coexistence of high MACC1 and low NM23-H1 expression and tumor budding was associated with short overall survival PMID: 29700912
- elevated NDKA was associated with severe characteristics of adenomas (>/=3 lesions, size >/= 1 cm or villous component). Setting specificity to 85%, NDKA showed a sensitivity of 30.19% and 29.82% for advanced adenomas and advanced neoplasia, respectively. PMID: 27222072
- This study suggested that EGFR was an important predictive factor for the prognosis of the post-operative patients with colorectal carcinoma TNM stage I-II, and nm23 is important for predicting the prognosis of the patients with stage III-IV; it is better that EGFR and nm23 are as predictor of combination. PMID: 27888614
- Results demonstrate that nm23 plays a vital role in decidualization in mice and humans and that nm23 gene expression is hormonally regulated. PMID: 27604954
- NM23 might be an indicator of good prognosis in patients with breast cancer, although further researches need to be performed to confirm the prognostic value of NM23. [Meta-analysis; review] PMID: 28161101
- The data presented suggest an important role for cytoplasmic IRF6 in regulating the availability or localization of the NME1/2 complex and thus the dynamic behavior of epithelia during lip/palate development. PMID: 28767310
- High NME1 expression is associated with well tumor differentiation in Digestive System Neoplasms PMID: 27518571
- Hepatitis C Virus E1 protein expression and HCV infection induces pro-metastatic effect on cancer cells which is simultaneous to Nm23-H1 transcriptional down-regulation and Nm23-H1 protein degradation. PMID: 28376369
- Meta-analysis showed that low expression of nm23-H1 is associated with poorer prognosis in patients with nasopharyngeal carcinoma, suggesting that it is a prognostic factor and potential biomarker for survival in nasopharyngeal carcinoma. PMID: 28614246
- Nm23-H1 nuclear localized mainly in the G2/M phase and the nuclear Nm23-H1 promoted A549 cell proliferation in vitro. PMID: 28442010
- Differential regulation of NM23-H1 may corroborate/abrogate EMT depending on the nature of stress, tumor microenvironment and cellular context. PMID: 28216015
- large-scale and well-designed studies, which use uniform antibody and criterion of NM23 positive expression, are required to further validate the role of the NM23 in predicting gastric cancer progression. PMID: 28401162
- Study reveals that NME1L may perform potent biological roles on the cellular behaviors through the extra N-terminal region as well as hexameric conformation. Because the N-terminal region itself has no effect on NF-kappaB signaling, the dimerization of NME1L is likely a pivotal process to confer the IKKbeta binding ability and subsequent regulation of NF-kappaB signaling on the region. PMID: 27094059
- A strong association between NME1 heterozygous genotype and breast cancer risk in Kashmiri population PMID: 27509166
- Down-regulation of Dyn1 activity enhances extracellular Nme1 in human colon tumor cell lines. PMID: 27449069
- nm23-H1 and MMP-2 may be as an indicator for esophageal cancer metastasis and prognosis PMID: 27592483
- Results confirmed that NME1L, but not NME1, is likely responsible for regulating breast cancer cell growth by inhibiting IGF1-stimulated ERK phosphorylation through N-terminal 25 amino acid-mediated interaction with KSR1. PMID: 26565392
- CRC patients with NM23-positive tumors had a better prognosis, and thus NM23 expression maybe used as a key prognostic indicator for CRC. PMID: 26634527
- NM23 expression is reduced in CRC tissues and low NM23 levels tightly correlate with higher Dukes stages, poorer differentiation grade, and positive lymph node metastases. PMID: 26825905
- Fibronectin is an important effector of the motility-suppressing function of NME1 in melanoma cells. PMID: 25808322
- Nm23 loss could be associated with a more favorable environment for the development and dissemination of breast cancer PMID: 25321081
- Dual functions of NME1 in suppression of cell motility and enhancement of genomic stability in melanoma PMID: 25017017
- Regulation of the metastasis suppressor Nm23-H1 by tumor viruses PMID: 25199839
- nm23-H1 protein may be an important prognostic factor in peripheral T-cell lymphoma, not otherwise specified;the nm23-H1-positive group had significantly shorter overall survival (Review). PMID: 25501107
- The case for extracellular Nm23-H1 as a driver of acute myeloid leukemia (AML) progression PMID: 25119778
- Interaction between Nm23 and the tumor suppressor VHL PMID: 24915993
- Using the described method for detecting histidine and aspartic acid phosphorylations and our prostate cancer progression cell system, the potential function of NM23-H1 in suppressing metastasis with a two-component regulation system is discussed PMID: 25373728
- The metastasis suppressor NME1 regulates expression of genes linked to metastasis and patient outcome in melanoma and breast carcinoma. PMID: 25048347
- NM23-H1 may participate in head and neck squamous cell carcinoma cell responses to cisplatin and be considered a potential therapeutic target. PMID: 25277180
- NM23H1 gene suppresses hyperplasia and metastasis of prostate cancer, thereby improving the survival rate. PMID: 24858271
- Overexpression of Nm23H1 did not affect tumorigenesis in nude mice assays, while overexpression of Nm23H2 enhanced tumor growth with elevated expression of the c-Myc proto-oncogene. PMID: 25748386
- NDPK-A was not able to bind to model membranes mimicking the inner leaflet of plasma membrane, suggesting that its in vivo membrane association is mediated by a non-lipidic partner or other partners than the studied phospholipids. PMID: 25010650
- Data shows that c-Abl and Arg induce NM23-H1 degradation by increasing expression and activation of cathepsin L and B, which directly cleave NM23-H1 in the lysosome. PMID: 24096484
- NME1L is a potent antimetastatic protein and may be a useful weapon in the fight against cancers. PMID: 24811176
- findings show NDPKs (NM23-H1/H2/H4) interact with and provide GTP to dynamins, allowing these motor proteins to work with high thermodynamic efficiency for membrane remodeling PMID: 24970086
- abnormal lower expression of NME1 in endometriotic stromal cells leads to more secretion of IL-8 and VEGF, up-regulates the level of CD62E and CD105, and leads to angiogenesis of vascular endothelial cells, which promotes development of endometriosis. PMID: 24133580
- Abnormally low expression of NME1 in endometrial stromal cells (ESCs) may be involved in the pathogenesis of endometriosis by up-regulating growth, adhesion and invasion of ESCs. PMID: 23856325
- Positive expression of Nm23 protein was found in ovarian tissue in 77.7 % cases in BRCA1 mutation carriers and in 90.9 % in the control group. PMID: 23553196
- NM23 suppressor protein may have a role in gastric carcinoma pathogenes PMID: 23725501
- In laryngeal squamous cell carcinoma patients, the disease recurrence rate correlates inversely with nuclear nm23-H1 expression. PMID: 23768014
- Data indicate that the activation of MAPK and PI3K pathways resulted in TGF-beta1 signaling by down-regulating Nm23-H1 expression and up-regulating the expression of TbetaRI and TbetaRII, favoring further activation of multiple signaling pathways. PMID: 23734265
- High NM23-H1 expression is associated with radioresistance in nasopharyngeal carcinoma. PMID: 23464856
- High NM23 expression is associated with sporadic colorectal cancer. PMID: 23679306
- Reduced nm23 immunohistochemical expression is an independent negative prognostic factor for overall survival and progression-free survival in invasive breast cancer. PMID: 23818346
- The crystal structure of oxidized Nm23-H1 is presented. It reveals the formation of an intramolecular disulfide bond between Cys4 and Cys145 that triggers a large conformational change that destabilizes the hexameric state. PMID: 23519676
- NM23 demonstrated no discriminatory value in the interpretation of lymph node nevus rests. PMID: 23694823
顯示更多
收起更多
-
亞細(xì)胞定位:Cytoplasm. Nucleus. Note=Cell-cycle dependent nuclear localization which can be induced by interaction with Epstein-barr viral proteins or by degradation of the SET complex by GzmA.
-
蛋白家族:NDK family
-
組織特異性:Isoform 1 is expressed in heart, brain, placenta, lung, liver, skeletal muscle, pancreas, spleen and thymus. Expressed in lung carcinoma cell lines but not in normal lung tissues. Isoform 2 is ubiquitously expressed and its expression is also related to t
-
數(shù)據(jù)庫鏈接:
Most popular with customers
-
-
YWHAB Recombinant Monoclonal Antibody
Applications: ELISA, WB, IHC, IF, FC
Species Reactivity: Human, Mouse, Rat
-
-
-
-
-
-